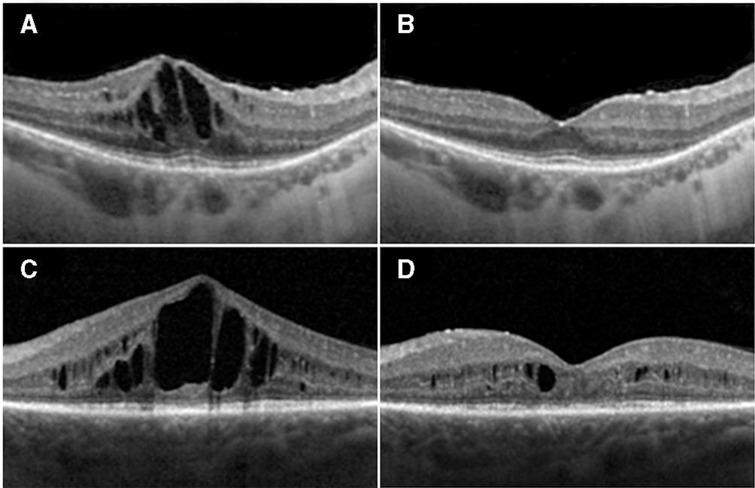

前瞻性探索性研究评估阿柏西普治疗与色素性视网膜炎相关的囊样黄斑水肿的安全性和有效性。
Prospective exploratory study to assess the safety and efficacy of aflibercept in cystoid macular oedema associated with retinitis pigmentosa.
机构信息
UCL Institute of Ophthalmology, University College London, London, UK.
Moorfields Eye Hospital, London, UK.
出版信息
Br J Ophthalmol. 2020 Sep;104(9):1203-1208. doi: 10.1136/bjophthalmol-2019-315152. Epub 2020 Feb 10.
AIMS
To report the safety and efficacy of intravitreal aflibercept (Eylea) (ivA) for retinitis pigmentosa-associated cystoid macular oedema (RP-CMO) at 12 months via mean central macular thickness (CMT) and reported adverse events.
METHODS
A prospective, exploratory, phase II, non-randomised, single-centre, open-label, 1-arm clinical trial involving 30 eyes of 30 patients. Serial ivA was given via loading dose (three injections) followed by treat and extend protocol over 12 months.
RESULTS
Twenty-nine out of 30 (96.7%) patients completed 12 months of follow-up. A total of four to 11 injections per patient were given over the 12 month study. No statistically significant reduction of CMT or visual acuity (VA) improvement was demonstrated in the group overall. Eleven out of 29 (37.9%) participants were considered as 'responders', demonstrating at least an 11% reduction of CMT at 12 months on spectral domain optical coherence tomography compared with baseline. A reduction of CMT by mean (SD) 28.1% (12.9 %) was observed in responders at 12 months, however, no statistically significant corresponding improvement in best corrected VA was seen. Baseline characteristics were similar between responder and non-responder groups. No clinically significant adverse events were deemed secondary to ivA.
CONCLUSION
This first prospective exploratory study demonstrates both the safety and acceptability of serial ivA in patients with RP-CMO, effective at reducing CMT in 37.9% of patients. All patients demonstrating anatomical response did so after their first injection. Longer duration of CMO did not negatively affect response to anti-VEGF. Further study in a larger cohort of patients with shorter CMO duration would be valuable to better establish the utility of VEGF blockade in RP-CMO.
TRIAL REGISTRATION NUMBERS
EudraCT (2015-003723-65); ClinicalTrials.gov (NCT02661711).
目的
通过平均中心视网膜厚度(CMT)和报告的不良事件,报告玻璃体内注射阿柏西普(艾力雅)(ivA)治疗色素性视网膜炎相关性囊样黄斑水肿(RP-CMO)在 12 个月时的安全性和疗效。
方法
这是一项前瞻性、探索性、二期、非随机、单中心、开放性、单臂临床试验,涉及 30 例 30 只眼的患者。连续玻璃体内注射艾力雅,先给予负荷剂量(三次注射),然后根据治疗和扩展方案在 12 个月内进行治疗。
结果
29 只眼(96.7%)完成了 12 个月的随访。在 12 个月的研究中,每位患者共接受了 4 至 11 次注射。总体上,CMT 或视力(VA)的改善没有统计学意义。29 例中有 11 例(37.9%)被认为是“应答者”,与基线相比,在 12 个月时,光谱域光学相干断层扫描(SD-OCT)上 CMT 至少降低了 11%。12 个月时,应答者的 CMT 平均(SD)降低了 28.1%(12.9%),但最佳矫正 VA 没有统计学意义的相应改善。应答者和无应答者组的基线特征相似。没有临床意义的不良事件被认为与 ivA 无关。
结论
这是第一项前瞻性探索性研究,证明了连续玻璃体内注射艾力雅在 RP-CMO 患者中的安全性和可接受性,可有效降低 37.9%患者的 CMT。所有表现出解剖学应答的患者在第一次注射后均出现应答。CMO 持续时间较长不会对抗 VEGF 治疗的效果产生负面影响。在较短 CMO 持续时间的更大患者队列中进行进一步研究,将有助于更好地确定 VEGF 阻断在 RP-CMO 中的作用。
试验注册号
EudraCT(2015-003723-65);ClinicalTrials.gov(NCT02661711)。